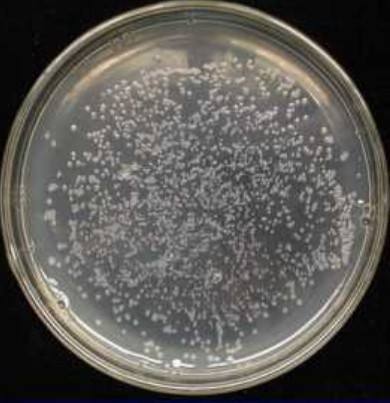
lb培养基中文名是什么

LB固体培养基

lb培养基是什么
图片尺寸650x347
lb培养基其他生物学相关
图片尺寸640x480
lb培养基求问这是什么菌
图片尺寸3024x4032
lb培养基求问这是什么菌
图片尺寸3024x4032
对于固体培养基ph监测,可使用平头电极或固液两用电极.
图片尺寸1080x1071
lb培养基中文名是什么
图片尺寸390x403
lb 固体培养基(干粉)
图片尺寸1000x1000
lb lennox固体培养基粉剂 1l 科研实验试剂 现货
图片尺寸1080x1080
lb 肉汤培养基
图片尺寸1200x1600
lb营养琼脂配方lb固体培养基作用中海生物
图片尺寸520x520
生物实验现象 配的培养基颜色怎么不对啊?
图片尺寸500x374
但是养菌养了几次了,总是养不好,步骤这些的都不可能出错嘛,lb培养基
图片尺寸675x900
lb营养琼脂l8290lb培养基lb固体培养索莱宝
图片尺寸973x973![lb固体培养基 (干粉) 肉汤 科研专用 细菌培养 [ph0639 phygene]](https://i.ecywang.com/upload/0/t14.baidu.com/it/u=4120369369,4063587167&fm=224&app=112&f=JPEG?w=500&h=500)
lb固体培养基 (干粉) 肉汤 科研专用 细菌培养 [ph0639 phygene]
图片尺寸800x800
培养基(其他生物相关)
图片尺寸300x293
lb培养基
图片尺寸2560x1440
支原体固体培养基使用说明
图片尺寸496x333
牛脑浸粉beefbraininfusion
图片尺寸1666x2246
l1015-1l*10 solarbio lb固体培养基(干粉)
图片尺寸500x500
连接转化入大肠杆菌dh5α感受态,lb培养基涂板.
图片尺寸3024x4032













![lb固体培养基 (干粉) 肉汤 科研专用 细菌培养 [ph0639 phygene]](https://i.ecywang.com/upload/0/t14.baidu.com/it/u=4120369369,4063587167&fm=224&app=112&f=JPEG?w=500&h=500)

![lb固体培养基 (干粉) 肉汤 科研专用 细菌培养 [ph0639 phygene]](https://img.alicdn.com/bao/uploaded/i1/3526625585/O1CN01XFyLpU1r7ypLvMKRB_!!0-item_pic.jpg)





